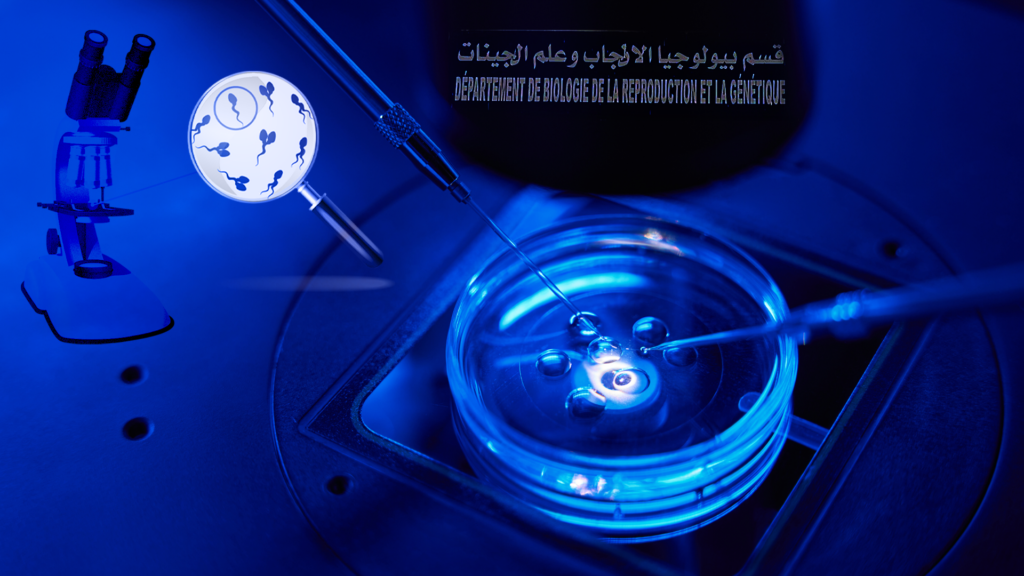

الكاتب : سناء عدوني
صحفية وباحثة في العلوم السياسيّة. شغلت عديد الخطط في الصحافة العربية والدولية.
“لم يقبل عقلي فقدان الأمل رغم فشل المحاولات، لم يدفعني التعب والضغط النفسي والعائلي إلى فقدان الثقة في الطبيب المباشر لحالتي، كان حلم الأمومة شحنة الأمل التي تنسيني أوجاع حصص الكشف بالصدى ومرارة العقاقير، كانت صور الأطفال في مخيّلتي نفخة الروح للمحاولة من جديد.. في كل بويضة أفقدها مع كلّ دورة شهريّة، أخاطب نفسي، هذا طفلي الذي لم تكتب له الحياة، لكنّني سأواصل المحاولة ولن أكفّ عن الأمل.”
سامية (اسم مستعار) هي سيّدة ثلاثينية، تعذّر عليها الإنجاب بعد زواجها في سنّ الـ28 حيث أثبتت الفحوصات الطبّية عدم قدرة السائل المنوي لشريكها على تلقيح بويضاتها، ما دفعها إلى القيام بالتلقيح في مخابر الطب الإنجابي أي ما يعرف بالحقن المجهري بمعيّة دكتور مختصّ.
تضيف سامية في حديثها لموقع الكتيبة: “أمضيت خمس سنوات دون إنجاب عايشت خلالها متلازمة نوبات هلع تقضّ مضجعي كلّ ليلة، كانت صور الأطفال تسكن مخيّلتي ليلا والأسئلة عن الحفيد الأوّل المنتظر تُمطرني نهارا”.
الكاتب : سناء عدوني
صحفية وباحثة في العلوم السياسيّة. شغلت عديد الخطط في الصحافة العربية والدولية.
“لم يقبل عقلي فقدان الأمل رغم فشل المحاولات، لم يدفعني التعب والضغط النفسي والعائلي إلى فقدان الثقة في الطبيب المباشر لحالتي، كان حلم الأمومة شحنة الأمل التي تنسيني أوجاع حصص الكشف بالصدى ومرارة العقاقير، كانت صور الأطفال في مخيّلتي نفخة الروح للمحاولة من جديد.. في كل بويضة أفقدها مع كلّ دورة شهريّة، أخاطب نفسي، هذا طفلي الذي لم تكتب له الحياة، لكنّني سأواصل المحاولة ولن أكفّ عن الأمل.”
سامية (اسم مستعار) هي سيّدة ثلاثينية، تعذّر عليها الإنجاب بعد زواجها في سنّ الـ28 حيث أثبتت الفحوصات الطبّية عدم قدرة السائل المنوي لشريكها على تلقيح بويضاتها، ما دفعها إلى القيام بالتلقيح في مخابر الطب الإنجابي أي ما يعرف بالحقن المجهري بمعيّة دكتور مختصّ.
تضيف سامية في حديثها لموقع الكتيبة: “أمضيت خمس سنوات دون إنجاب عايشت خلالها متلازمة نوبات هلع تقضّ مضجعي كلّ ليلة، كانت صور الأطفال تسكن مخيّلتي ليلا والأسئلة عن الحفيد الأوّل المنتظر تُمطرني نهارا”.


رحلة مضنية في سراديب المخابر
اختصرت محدّثتنا المسافات، فمنذ السنة الأولى و بإدراكها هي وزوجها استحالة حصول الحمل بطريقة طبيعيّة، توجّهت سامية إلى طبيب مختصّ للقيام بعمليّة زرع داخل إحدى المخابر الخاصة.
تتحدّث سامية عن تجربتها قائلة :”تجربة الحقن المجهري من أصعب مراحل حياتي، قضيت أربع سنوات أقوم بعمليّات زرع بصفة روتينيّة متواصلة وأفشل. وفي كلّ فشل كنت أروّض غريزة الأمومة داخلي بقولي لعلّ هذا الجنين كان قد يولد مريضا أو مشوّها”.
كانت صور الأطفال تسكن مخيّلتي ليلا والأسئلة عن الحفيد الأوّل المنتظر تُمطرني نهارا
سامية
بالتزامن مع فترة الحقن، سعت سامية لملء وقتها حيث توضّح قائلة : “قمت بأنشطة عديدة مثل القراءة والعزف تفاديا للأذى النفسي الذي تسبّبه لي ضغوط الناس، فالفراغ كان بالنّسبة إليّ دوامة السوداوية وتذكّر نظرات الشفقة التي أتلقّاها يوميّا.”
أمومة عسيرة
يُعرّف الحقن المجهري بأنّه تقنيّة مساعدة على الإنجاب تهدف إلى إحداث تلاق بين الحيوانات المنوية والبويضات، أي حدوث التلقيح في المختبر لتعويض عدم حصوله داخل تجويف الرّحم بسبب ضعف في الحيوانات المنويّة أو إشكاليات أخرى مثل بطانة الرحم المهاجرة والتي تحول دون حدوث الحمل طبيعيّا، وهو يعدّ من بين التقنيّات الأكثر تطوّرا في الطبّ الإنجابي.
تكوين الأجنّة يقع في المخبر بعد 5 أيام من إتمام الزّرع ممّا يعني أنّ الحقن المجهري هو وقوع التلقيح تحت المجهر.
الدكتور محمد خروف
يوضّح الدكتور محمد خروف المختصّ في طب النساء والتوليد والمساعدة على الإنجاب أنّ تقنية الحقن المجهري (التلقيح المجهري) تعتمد على اختيار حيوان منوي واحد من عيّنة السائل المنوي قبل أن يتمّ حقنه مباشرة في البويضة بواسطة إبرة مجهريّة، تُنقل الأجنّة إلى رحم المرأة بعد التأكد من وقوع الانقسام الخلوي بشكل سليم. ثم تقع عمليّة تكوين الأجنّة في المخبر بعد 5 أيام كأقصى تقدير من إتمام الزرع ما يعني أنّ التلقيح المجهري هو وقوع التلقيح تحت المجهر” .
أمّا التلقيح الاصطناعي فهو حسب الدكتور خروف آليّة أقرب للإلقاح الطبيعي إذ يتمّ استخدام هرمونات لتحفيز البويضات على إنتاج عدد أكبر من البويضات في الدّورة الشهرية ويتمّ خلط الحيوانات المنويّة الأكثر نشاطا مع البويضات في حاضنات خاصّة، ثمّ الانتظار حتى يتمكّن أحد الحيوانات المنوية من اختراق جدار البويضة وتلقيحها طبيعيّا دون تدخّل طبّي مباشر.


ويكمن الاختلاف بين الآليّتين في التلقيح، ففي حالة الحقن المجهري يضع الطبيب الحيوانات المنوية ذات الجودة العالية مع البويضات ذات الجودة العالية لحدوث التلقيح في المختبر، وتحفظ البويضة الملقّحة في كلتا الحالتين في المختبر لمدة 2 إلى 5 أيام لتنمو الأجنّة. لكنّها في حالة التلقيح الاصطناعي، تتمّ خلال ساعات. إذ يختار حيوان منوي واحد في إبرة زجاجيّة ويتمّ حقنه مباشرة في كلّ بويضة، وفي الحالتين يقع حقن الأم بهرمون البروجسترون لتهيئة الرحم لاستقبال البويضة.
ومن شروط نجاح التلقيح الاصطناعي صغر سنّ المرأة وجودة نسبيّة للمني فيما تبلغ نسبة نجاحها حسب الدكتور خروف 15 %. وكلّما كان عدد الحيوانات المنويّة ضئيلا تنحدر نسبة نجاح هذه الآليّة.
وحسب الدكتور خروف تبلغ نسبة نجاح الحقن المجهري في كل محاولة 50 % خلال العام 2023. كما تتطوّر إلى 80 % في الحالات غير المستعصية ذات الخصوبة العالية حيث يعتبر عامل السن محوريّا في ضمان تكوين أجنّة قادرة على إنتاج الحمل والولادة.
ويوضّح نفس المصدر الحالات التي تستحيل معها آليّات المساعدة على الإنجاب وهي حالات عدم وجود حيوانات منويّة في الخصيتين والنفاذ الكامل لمخزون البويضات.
القطاع الخاصّ.. لمن استطاع إليه سبيلا
تُعتبر التّكلفة الماليّة للحقن المجهري باهظة في القطاع الخاصّ حسب ما تنقله لنا سامية التي تقول إن “التّحاليل والفحوصات تصل إلى ثلاثة آلاف دينار (حوالي 1000 دولار أمريكي) ويتولّى الصندوق الوطني للتأمين على المرض في إطار نظام استرجاع المصاريف تعويض 250 دينارا (حوالي 80 دولارا أمريكيا) فقط عن كلّ عمليّة للمضمون الاجتماعي”.
في المقابل، تقدّر كلفة الكشف بالصدى بـ 600 دينارًا (حوالي 200 دولار أمريكي ) غير خاضعة لنظام استرجاع المصاريف ولا يمكن التمتّع بنظام استرجاع المصاريف بالنسبة إلى الحصول على أدوية تنشيط البويضات مرتفعة السعر إلاّ خلال ثلاث محاولات تكون مشروطة بعمر محدّد للمرأة بأقلّ من أربعين سنة وفق مختلف المصادر الطبّية.
يحقّ للمرأة الحصول على أدوية تنشيط البويضات بتغطية صندوق التأمين على المرض ثلاث مرات تكون مشروطة بعمر أقلّ من أربعين سنة.
مصادر طبية
وبالعودة إلى تجربة سامية، فقد واظبت في تلك الفترة على إجراء فحوصات كلّ يومين حيث تبلغ تكلفة الفحص الواحد 80 دينارًا (حوالي 25 دولارا أمريكي) تقع جميعها على عاتقها وخارج دائرة التغطية الاجتماعية للصندوق الوطني للتأمين على المرض وتحمّلت وزوجها تلك الكلفة، في خضمّ ذلك تجنّبت محدّثتنا إبلاغ العائلة لتفادي ما ينجرّ من إحباط عن احتمال فشل الحقن.
في النهاية نجحت سامية في إنجاب طفليها عبر آليّة الحقن المجهري خلال عمليّة تنشيط البويضات الثانية وفي الزرع الخامس واليوم هي أمّ لطفلين هما ثمار لولادة باهظة الفاتورة الجسديّة والنفسيّة والماليّة. لكن عمق الشعور بالأمومة كان بلسما لكل الأوجاع.


مراكز عموميّة أقل كُلفة
تبيّن الأستاذة المبرّزة في علم الأنسجة والأجنّة وبيولوجيا الإنجاب في مستشفى عزيزة عثمانة خديجة بالرجب أنّه بالنسبة الى المنخرطين في منظومة صندوق التأمين على المرض فإنّ كلفة عمليّة الحقن تبلغ 250 دينارًا فقط (حوالي 80 دولار أمريكي)، إضافة إلى مجّانية أدوية التّنشيط حيث يتولّى الصندوق الوطني للتأمين على المرض تغطيتها في ثلاث محاولات كما ذُكر سابقا.
ونظرا إلى انخفاض كلفته، يقوم مستشفى عزيزة عثمانة، الذي يحتوي على أبرز مراكز المساعدة على الإنجاب في تونس، بما بين 800 و 900 عمليّة حقن مجهري سنويّا، تصل نسبة نجاحها إلى 35 % وأحيانا 40 % كلّما كان عامل السنّ أصغر بالنّسبة الى النساء وجودة الحيوانات المنويّة أفضل بالنسبة للرجال.


أمّا مستشفى فرحات حشّاد بسوسة الذي يحتوي على ثاني أكبر مركز مساعدة على الإنجاب، فتبلغ عمليّات الحقن السنوية فيه 750 حالة فيما تبلغ تكلفة عمليّات الحقن 550 دينارا (أقل من 200 دولار أمريكي) حسب تصريح الدكتور هادي خيري عميد كلية الطّب بسوسة ورئيس قسم النساء والتوليد بالمستشفى المذكور.
يضيف الدكتور هادي خيري أنه كان بإمكان المستشفى تنفيذ عدد أكبر من عمليات الحقن في إطار برنامج الدولة للمساعدة على الإنجاب غير أنّ محدوديّة الإطارات الطبّية وشبه الطبّية تعرقل ذلك بسبب توقف الانتداب في القطاع العام، فضلا عن اقتصار هذه المراكز على مستشفيات عزيزة عثمانة بالعاصمة وفرحات حشاد بسوسة ومركز بمستشفى الهادي شاكر بمدينة صفاقس والمستشفى العسكري بالعاصمة (يخصّ عائلات العسكريين).
محدثنا أشار كذلك إلى أنّ سياسة الصحّة الإنجابية التّي كانت سابقة للعصر في عديد المجالات كحقّ الإجهاض للتونسيات باتت تستحقّ اليوم مزيدا من التطوير في بعض المطبّات مثل العقبة التي ما تزال تواجه الشابات العازبات في تجميد بويضاتهن.
ويحيل ذلك الى نقائص وهنّات منظومة الصحة الإنجابية غير المتكافئة حيث تؤكد دراسة بعنوان سياسة الصحة الإنجابية في تونس: حق المرأة في الصحة الإنجابية والتمكين الجندري”، وهي منشورة على موقع “Health and Human rights journal” حول الحقوق الصحية للمرأة التونسية بين 1994 و 2014، بطء نسق تحسّن الصحة الإنجابية بين عامَي 1994 و 2008 من خلال احتساب عينة عن معدّل وفيات الأمهات في تونس (لكلّ 100.000 ولادة حية).
وقد أظهرت أنّها بلغت 44.8 في 2008 مقارنة بنحو 68.9 في 1994، الأمر الذي يؤكّد أيضا عدم تحقيق التطلّعات والنتائج المرجوّة لتحقيق سياسة صحّية ناجعة وتمكين صحّي ذي كفاءة خاصّة في مناطق الشمال الغربي والوسط.
كفالة الأطفال .. عندما تتحدّى المرأة التونسيّة الأفكار الرجعيّة
في تجربة أخرى مختلفة في معانيها وقيمها، تسرد لنا حنان (اسم مستعار) قصّتها في صناعة أمل من خارج بوتقة الإنجاب كفعل معبّر عن كماليّة المرأة بهدف إرضاء مجتمع لا يرى المرأة خارج الوظيفة الإنجابية.
أرفض فكرة أنّ المرأة لا يمكن أن تكتمل إلا عندما تصبح أمّا، وأنّها لن تكون سعيدة دون أطفال.
حنان
دحضت حنان الأفكار الشائعة التي ترى أنّ المرأة لا يمكن أن تكتمل إلا عندما تصبح أمّا، وأنّه دون أطفال لا يمكنها أن تكون سعيدة وتعيش بسلام، وأنّ الحبّ الحقيقي هو ذاك الذي نختبره كأمّهات بيولوجيّات فقط. وإن لم يتحقّق، فكأنّ ذلك دلالة على الأنانية أو الفشل.
تقول محدثتنا بنبرة واثقة: ”لم أتمّم عمليّة الحقن طوعا وخيّرت أن أكفل طفلا أهبه حياةً أفضل على أن أكون أمًّا بيولوجية تلبية لنهم غريزة فطريّة تحضّ البشر على الإنجاب إرضاء لمجتمع يرانا كائنا إنجابيا أو لا نكون.”
ويكشف فيديو تسنى لموقع الكتيبة الإطلاع عليه للحظة استقبال حنان وزوجها لطفلتهما في أوّل لقاء عمق التعاطف الإنساني حيث تلخّص حنان مشاعر مركّبة من الفرح والغبطة والوجع بقولها: “لم أنم طيلة الليل في انتظار رؤيتك.. إنّها نفس الطفلة التي رأيتها في منامي.”
توجّهت حنان إلى كفالة طفلة من قرية الأطفال بصفاقس سنة 2021 لكنّها ما تزال إلى اليوم تنتظر حُكمًا قضائيا من أجل تغيير اسم الطفلة وتسجيلها في التغطية والتأمين الصحّي الخاصّ بالعائلة وهي إلى حدّ اللحظة توفّر الرعاية الصحّية لطفلتها من تلاقيح وعلاج على حسابها الخاصّ ودون تعويضات الصناديق الاجتماعية.
تبرز قصّة حنان أنّ قرار إنجاب الأطفال ليس هو الخيار الوحيد، وهي اختارت الكفالة في تحدّ لسرديّة اختزالية تتطلّع إلى المرأة التي لم تنجب كحالةٍ شاذّة، أو كامرأة تحتاج الى الشفقة.
ويعرّف التشريع التونسي المتعلّق بالولاية العمومية والكفالة والتبنّي الكفالة بأنها عقد يقوم بمقتضاه شخص رشيد يتمتّع بكامل حقوقه المدنيّة بكفالة طفل قاصر فيبرم بموجبه عقد الكفالة بين الكفيل من جهة و أبوي المكفول أو أحدهما إذا كان الآخر ميّتا أو مجهولا أو عند الاقتضاء الوليّ العمومي أو من يمثّله من جهة أخرى ويصادق حاكم الناحية على عقد الكفالة.”
تعتبر المحامية والنّاشطة النّسوية حياة الجزّار أنّ “هذا القانون عكس شجاعة من المشرّع في ذلك الزمن لأنّه قانون وضعي عارض مواقف شيوخ الدّين وهو تتمّة لمجلّة الأحوال الشخصيّة التي أحدثت ثورة في الحياة الاجتماعية.”
تشير حياة الجزّار إلى أنّ هذا القانون هو مكسب واجه عديد التحدّيات وإلى اليوم يواجه معارضة أصحاب الخلفيّات الدينيّة المتشدّدة حتى من القضاة أنفسهم ممّن يتجنّبون التصريح بأحكام التبنّي باستعمال تعلّات واهية أو ضغوط على المحامين لأنّ حكم التبنّي نهائي وغير قابل للنقض وبعض القضاة يستبطنون ثقافة معادية للقوانين الوضعية التي تتعارض مع أحكام الشريعة الإسلامية.
وتشدّد الجزّار على أنّ التّونسيين اعتادوا الكفالة والتبنّي كتقليد إنساني يبرهن على الحب والعطاء، قائلة إنّ “إرادتهم أقوى من آلة الرجعيّة وقوى الجذب إلى الوراء”.
أنجر هذا المقال ضمن مشروع "مسارنا" بالشراكة مع منظمة "آر آن دبيلو" . وهو يندرج ضمن سلسلة تحقيقات ومقالات تفسيريّة يشتغل عليها موقع الكتيبة في علاقة بحقوق المرأة في تونس بشكل عام والصحّة الجنسية والإنجابية بشكل خاص.
أنجر هذا المقال ضمن مشروع "مسارنا" بالشراكة مع منظمة "آر آن دبيلو" . وهو يندرج ضمن سلسلة تحقيقات ومقالات تفسيريّة يشتغل عليها موقع الكتيبة في علاقة بحقوق المرأة في تونس بشكل عام والصحّة الجنسية والإنجابية بشكل خاص.

الكاتب : سناء عدوني
صحفية وباحثة في العلوم السياسيّة. شغلت عديد الخطط في الصحافة العربية والدولية.
الكاتب : سناء عدوني
صحفية وباحثة في العلوم السياسيّة. شغلت عديد الخطط في الصحافة العربية والدولية.